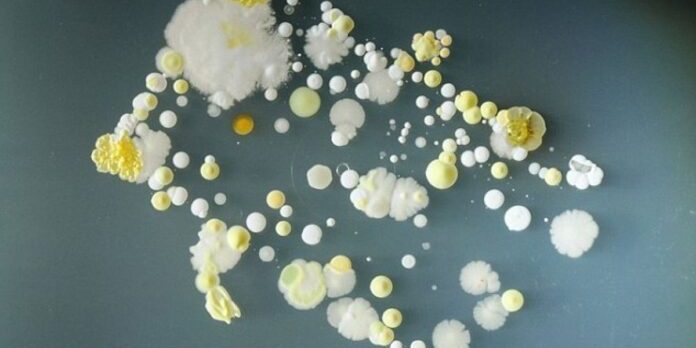
На смартфонах обнаружили опасные бактерии

На смартфонах обнаружили опасные бактерии

Учёные собрали мазки с поверхностей 100 мобильных телефонов студентов факультетов биомедицины.
Исследователи из Западного Университета в Сан-Паулу (Бразилия) нашли на смартфонах студентов-медиков множество бактерий, опасных как для самого медицинского персонала, так и для пациентов.
Учёные собрали мазки с поверхностей 100 мобильных телефонов студентов факультетов биомедицины, фармакологии, стоматологии, питания и сестринского дела. Оказалось, что 85% выделенных микробов имеют устойчивость к пенициллину, а половина из них отлично прилипают к поверхностям.
Это значит, что использование загрязнённых телефонов в больнице может обернуться тяжёлыми последствиями для персонала и пациентов.
Кроме того, на 40% смартфонов обнаружили бактерию S. aureus, или золотистый стафилококк. Она может вызывать целый спектр заболеваний, начиная от угрей и фурункулов, и заканчивая пневмонией или менингитом.
материал med2.ru